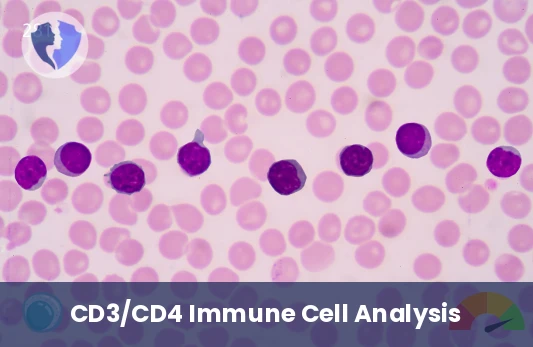
T-Cell Efficiency Test - CD3/CD4 Cell Count Test

Service Details
T-Cell Efficiency Test - CD3/CD4 Cell Count Test
CD3/CD4 analysis is a laboratory test used to evaluate the levels of T lymphocytes in the blood. CD3 is a common marker found on all T lymphocytes, while CD4 indicates a specific subset responsible for supporting and enhancing the immune response. The results of this test are mainly used in the diagnosis and monitoring of conditions such as human immunodeficiency virus (HIV) infection and autoimmune diseases, helping physicians assess immune system health and determine the need for treatment. This analysis is considered an important tool in modern medicine for understanding and guiding immunological therapies.